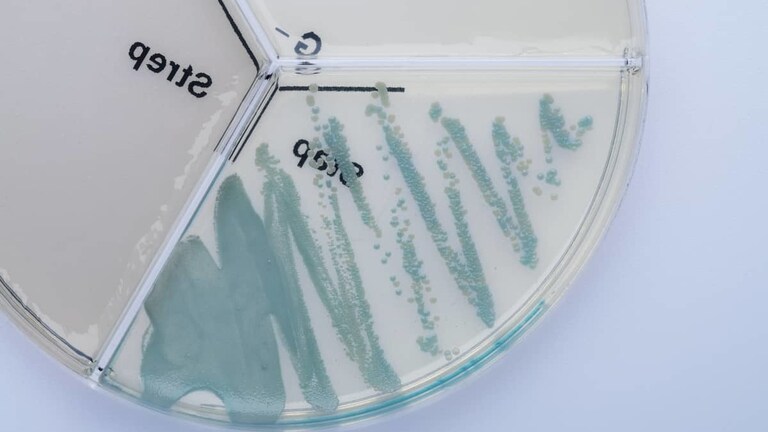
Staphylococcus xylosus ClearMilk Test

Staphylococcus xylosus from a coagulase-negative staphylococci group ranks among less common causal agents of subclinical mastitis (ca. less than 8%) in dairy cows. It can be found on the skin of more animal species; it is rare in humans. High hygiene standard of milking and a care for the mammary gland are the methods of prevention.